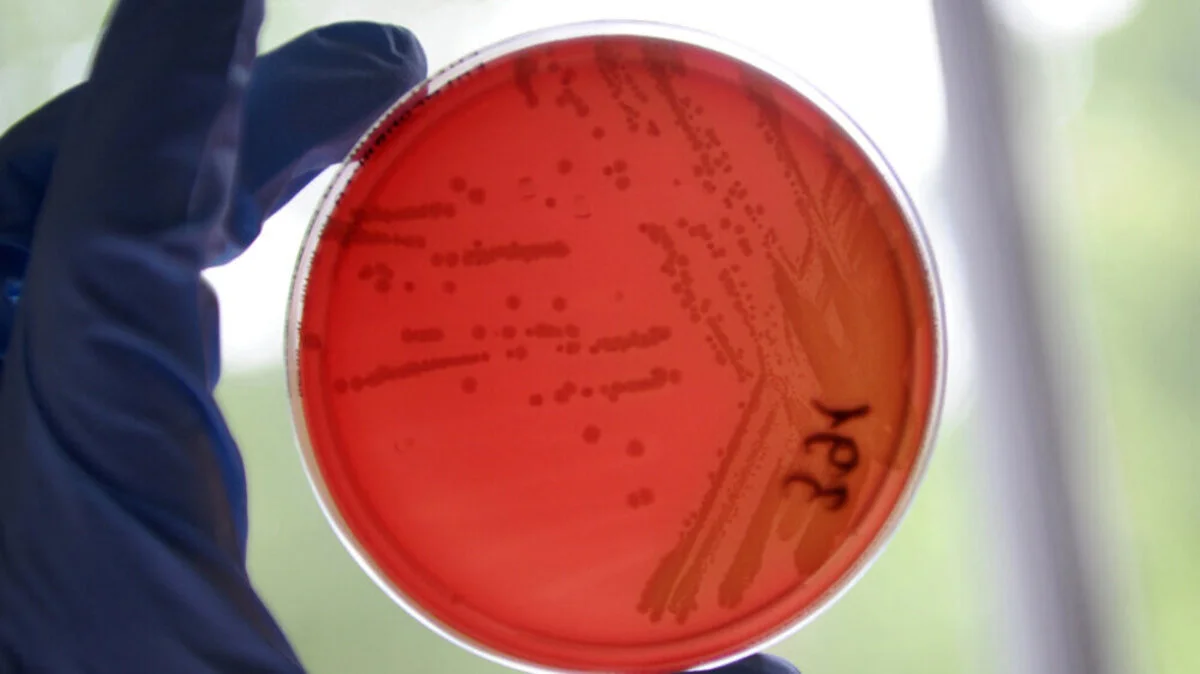
Produkt von Sorger in Hofer-Supermärkten verkauft | Produkt von Sorger in Hofer-Supermärkten verkauft

Wien
Landjäger-Würstel mit EHEC kontaminiert und zurückgerufen
Landjäger-Würstel, die in den Hofer-Supermärkten verkauft wurden, sind wegen einer Kontamination mit EHEC (Enterohämorrhagische Escherichia coli) zurückgerufen worden. Das Produkt war in Tirol, Vorarlberg, Salzburg, Kärnten, Steiermark und Südburgenland in den Filialen erhältlich. Der Verkauf des Produktes wurde sofort gestoppt, so die Agentur für Gesundheit und Ernährungssicherheit (AGES) am Freitag.
© APA/dpa